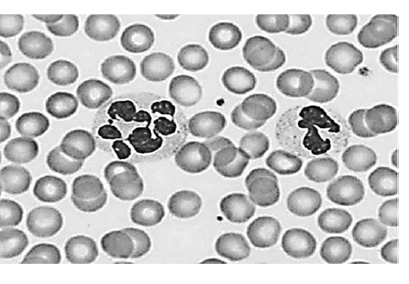
Enunciado 1681648-1

Foram encontradas 150 questões.
Um paciente de 22 anos de idade procurou o pronto-socorro por quadro de febre aferida, náuseas e dores pelo corpo há cinco dias. Referia viagem recente ao interior de São Paulo para realização de trilhas e visitas a cachoeiras. Ao exame, encontrava-se corado, hidratado, ictérico +++/4, febril (38,2 ºC), com frequência cardíaca de 68 bpm, PA de 110 x 70 mmHg e FR de 20 ipm.
Considerando essa situação hipotética, assinale a alternativa que apresenta, respectivamente, o exame que possibilitaria a definição diagnóstica e o tratamento.
Provas
Uma paciente de 23 anos de idade procurou o pronto-socorro por quadro de edema há três semanas. Referiu que, inicialmente, o edema localizava-se em membros inferiores, porém, após duas semanas, vinha notando um edema generalizado, até em face. Referiu ter ganhado peso, mas negou quaisquer outras queixas. Na investigação, foram realizados os seguintes exames: hemograma; creatinina; ureia; urina 1; relação proteína/creatinina em amostra isolada; complemento sérico; e sorologias para hepatite B, C, HIV e FAN. Os únicos exames alterados foram: urina 1, com proteinúria +++ e discretas hemácias dismórficas; relação proteína/creatinina = 6 g/g; e FAN positivo (padrão nuclear homogêneo altos títulos). Foi realizada, também, biópsia renal, que mostrou uma glomerulonefrite membranosa com uma imunofluorescência rica em deposição de IgG, IgM, C1q, C3 e C4 (padrão full house).
Considerando essa situação hipotética, assinale a alternativa que apresenta a melhor opção terapêutica para a paciente.
Provas
Um paciente de 65 anos de idade, com antecedente de tabagismo, hipertensão e dislipidemia, refere que, há um mês, vem notando o rosto inchado e vermelho ao se levantar pela manhã. Hoje cedo, foi auxiliar sua esposa a carregar um pacote pesado e descreveu uma sensação de “quase desmaio”, que o motivou a procurar o pronto-socorro. No exame físico: PA de 130 x 80 mmHg; FC de 70 bpm; FR de 22; e Sat. de 93%, notando-se ingurgitamento venoso cervical e edema craniofacial, além de edema discreto em MMSS. Não há edema em MMII. Ausculta cardiopulmonar e exame abdominal sem alterações. O ECG mostrou ritmo sinusal e FC igual a 70, sem alterações patológicas do traçado.
Com base nesse caso hipotético, a investigação deve ser conduzida com
Provas
Um paciente de 44 anos de idade, procedente da Bahia, refere rash maculopapular, febre, artralgia, conjuntivite não purulenta, petéquias e hematoespermia há sete dias. Está lúcido, orientado, com PA de 110 x 70 mmHg, FC de 98 bpm, SO2 de 94% e T. de 38,1 ºC. Foram realizados exames laboratoriais em conjunto com sorologias e pesquisa de vírus (zika, chikungunya e dengue). Após avaliação clínica-laboratorial, orientou-se alta hospitalar e retorno caso houvesse sinais de alarme. Comunicado posteriormente, o resultado dos exames foi RT-PCR positivo para zika. Foram instituídas medidas preventivas pelo serviço local. Após dois dias, apresentou acentuada fraqueza em membros inferiores, simétrica, de caráter progressivo, em conjunto com arreflexia e disfunção autonômica.
Com base nesse caso hipotético, é correto afirmar que
Provas
Um homem de 36 anos de idade, previamente hígido, vegetariano, refere fraqueza nos membros inferiores, instabilidade e dificuldade para caminhar, com quedas frequentes, há três meses. Nega trauma, dor cervical, uso de álcool ou drogas, febre, distúrbio convulsivo e uso de medicações. Segue em acompanhamento com dermatologista há oito anos por vitiligo. Após consulta com neurologista, solicitou exames laboratoriais (Hb 9,6 g/dL, VCM 131 fl, leucócitos 2.000/m3, plaquetas 80.000 m3, DHL 1.550 UI/L, bilirrubina indireta 2,6 mg/dL e direta 0,8 mg/dL, reticulóticos 1% e Coombs direto normal) e tomografia de crânio, que estava normal. Demais exames laboratoriais em andamento. Esfregaço de sangue periférico apresentado a seguir.
Considerando essa situação hipotética, assinale a alternativa correta.
Provas
Uma paciente de 46 anos de idade, com antecedente de doença celíaca e em uso irregular de metimazol, refere tratamento de pneumonia com amoxicilina, sem melhora significativa, há uma semana. Evoluiu, há três dias, com dispneia progressiva, associada à taquicardia (FC de 144 bpm e pulso irregular), T. de 39 graus, PA de 100 x 80 mmHg, confusão mental e icterícia. Ao exame físico, estertores até terço médio em ambos os hemitórax, sopro sistólico 2+/6 em foco mitral, dor abdominal difusa e edema em membros inferiores. Escore de 120 pontos na escala de Burch-Wartofsky.
Com base nesse caso hipotético, é correto afirmar que
Provas
Uma paciente de 28 anos de idade, obesa, apresenta inúmeras exacerbações graves da asma, inclusive com necessidade de ventilação mecânica.
Considerando essa situação hipotética, assinale a alternativa correta.
Provas
Provas
Um paciente de 82 anos de idade, portador de hipertensão arterial sistêmica mal controlada, em uso irregular de valsartana 160 mg/dia e hidroclorotiazida 25 mg/dia, foi admitido após relato de instalação súbita de fraqueza no hemicorpo direito há duas horas. Familiares negam história pregressa ou familiar de episódios semelhantes. Ao exame, apresentou PA de 194 x 120 mmHg, FC de 114 bpm, com pulso rítmico e cheio, e glicemia capilar 159 mg/dl. Ao exame neurológico, mostrou-se desatento e um pouco sonolento, com hemiplegia e anestesia completa à direita. Pupilas isocóricas e fotorreagentes. Ausência de nistagmo. Força muscular preservada à esquerda e sensibilidades superficial e profunda preservadas à esquerda. Sem outros achados alterados.
Com base nessa situação hipotética, assinale a alternativa correta.
Provas
Um paciente de 78 anos de idade, com antecedentes de hipertensão arterial refratária, diabetes e doença renal crônica dialítica, internado em unidade de terapia intensiva devido à acidente vascular hemorrágico há três dias, evoluiu com dispneia súbita e instabilidade hemodinâmica, com necessidade de intubação orotraqueal e droga vasoativa. Ecocardiograma transtorácico à beira do leito identificou imagem sugestiva de trombo em tronco da artéria pulmonar, com disfunção importante do ventrículo direito e hipertensão pulmonar.
Com base nesse caso hipotético, assinale a alternativa que apresenta a melhor conduta terapêutica para o paciente.
Provas
Caderno Container